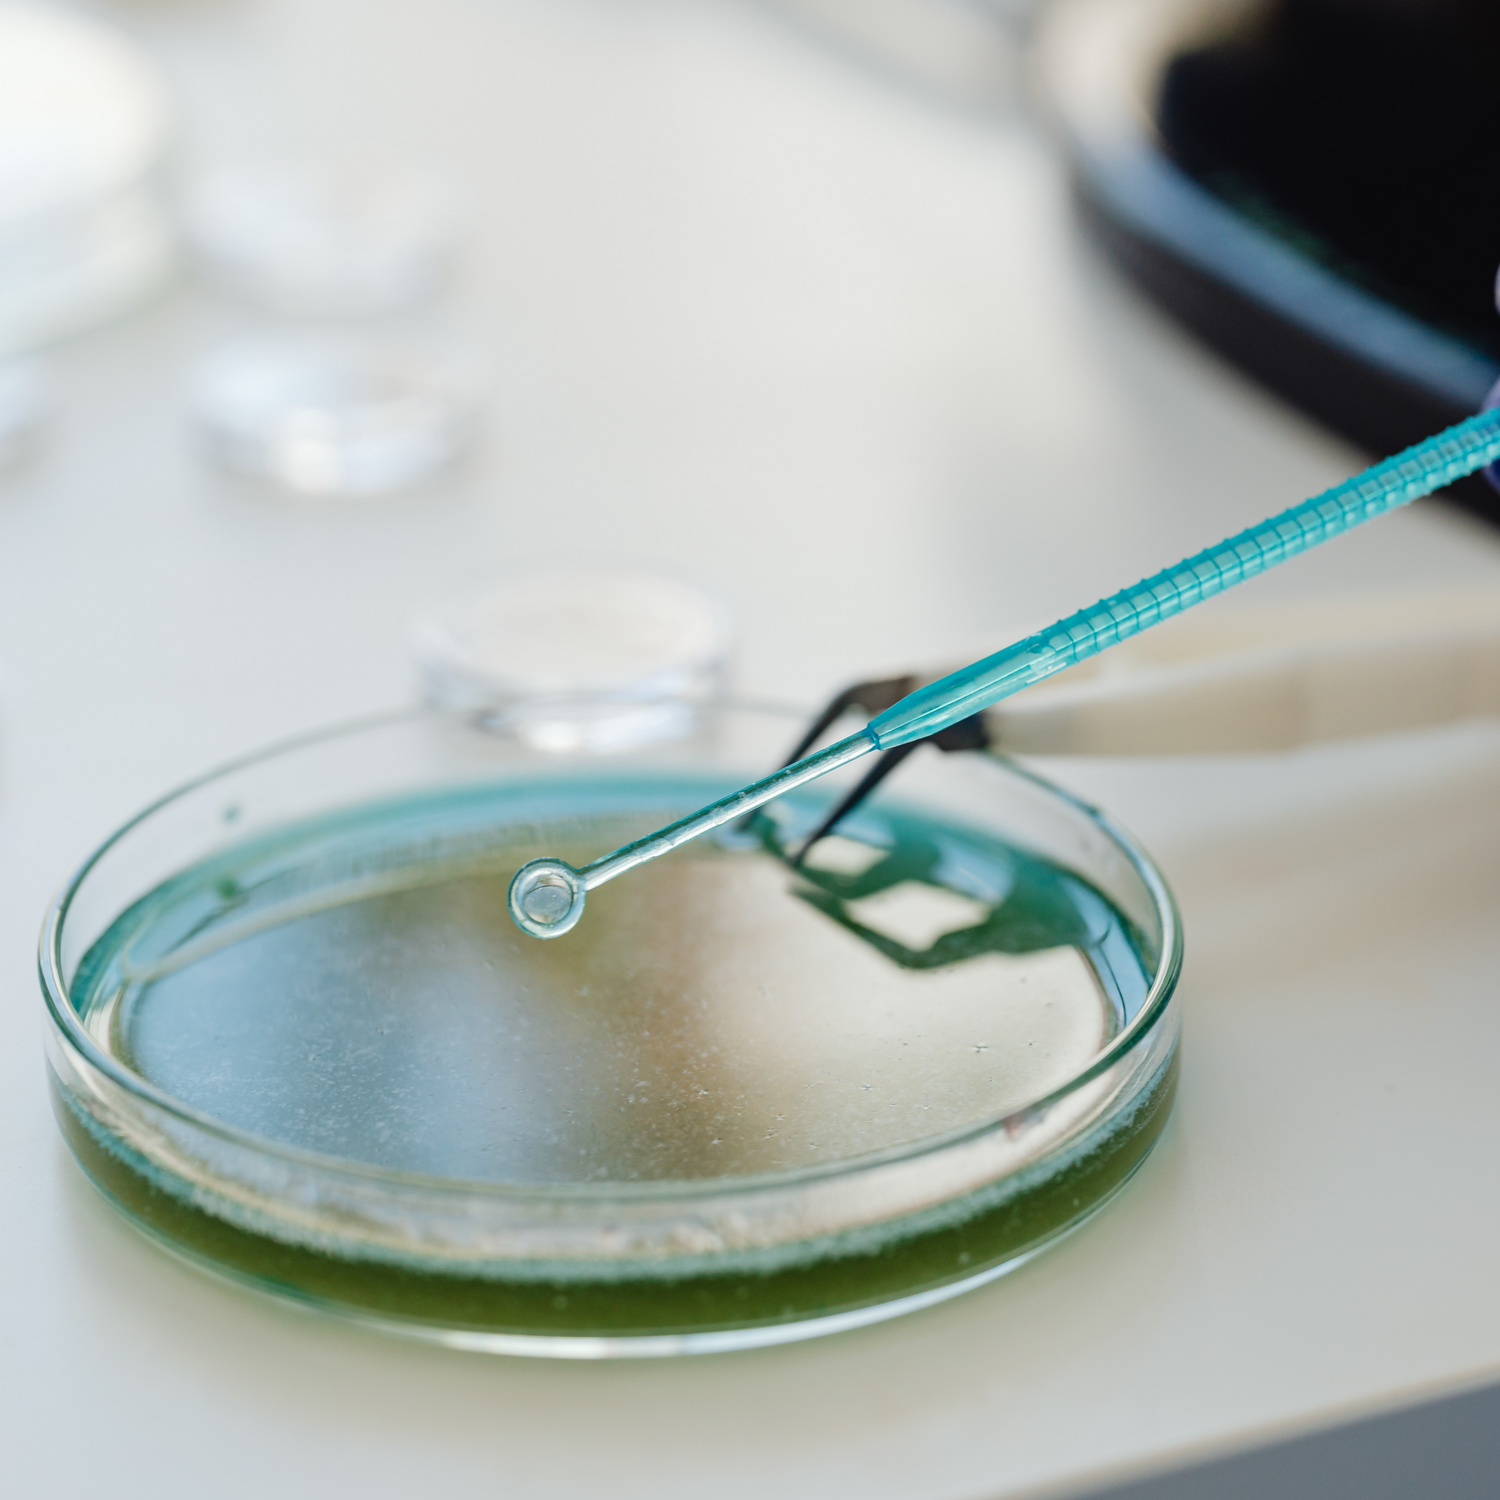

Prebiotics, Probiotics, Postbiotics - what are they??
Aside from all having “-biotic” in their names, each of these microbiome-related components have their own separate roles.
Let’s explore the core functions of each and the key differences between them…
Prebiotics: Non-digestible fibres that serve as food for the beneficial bacteria in our gut. By consuming prebiotics, we provide nourishment to the existing microbial residents, allowing them to flourish and promote a healthy microbiome environment.
Probiotics: Live and active microorganisms that, when consumed in adequate amounts, confer health benefits to the host (you!). These friendly bacteria help maintain the delicate balance of our microbiome- supporting digestion, immune system health, skin health, and making us feel better overall.
Postbiotics: The beneficial substances produced by probiotic bacteria during fermentation. These substances include organic acids, enzymes, vitamins, and other bioactive compounds that promote gut health and overall well-being. Think of them as the valuable byproducts of the microbial fermentation process. Postbiotics hold promise as therapeutic agents for various health conditions and contribute to the benefits observed from consuming beneficial bacteria.
What do postbiotics have to do with skincare?
Postbiotics are a relatively new area of interest in the field of skincare, representing a class of beneficial compounds that are produced when probiotics (live beneficial bacteria) metabolize prebiotics (fibers that serve as food for these bacteria).
They are generated by probiotic organisms such as bacterial and fungal species, the strains of which mainly include those of Lactobacillus, Bifidobacterium, Streptococcus, Eubacterium, Faecalibacterium, and Saccharomyces.
Postbiotics are often included in skincare formulations for several reasons.
- They can help maintain a balanced and healthy skin microbiome by providing the necessary nutrients and environment for beneficial microorganisms. AND they contribute to strengthening the skin barrier, which is essential for protecting the skin from external factors like pollutants and preventing moisture loss.
- Postbiotics also contribute to improved hydration by supporting the skin's ability to retain moisture, and certain postbiotics even have soothing properties, which can help alleviate redness and discomfort on the skin.

Including postbiotics in skincare products is part of the broader trend of promoting a holistic approach that considers the importance of the skin microbiome in maintaining skin health.
Have you ever considered using postbiotics in your skincare?

Using powerful and bioactive skincare, such as biomiq's postbiotic acne range, which actively instigates skin cell renewal will provide your skin with the nourishment and care it deserves. The signature postbiotics in biomiq's formula work hard to rebalance your skins natural microbiome. Not only treating common skin conditions, but also paving a future pathway to consistently clearer, more beautiful, healthier and toned skin.
Read our other blogs
-
Invisible Guardians: understanding the skin microbiome
Read ArticleThere is a fascinating world beneath the surface of our skin that is rarely discussed yet holds tremendous importance: the skin microbiome.
-
Cosmetic ingredients that your skin craves.
Read ArticleImagine having access to products designed to enhance your skin's health and shield you from harmful bacteria or irritants linked to common skin issues?
-
Skin Microbiome 101
Read ArticleNew technologies have enabled scientists to gain a better understanding of the importance of these tiny microscopic organisms to skin health. Just like the gut microbes are critical to our digestive health, these organisms play a pivotal role in keeping our skin healthy.